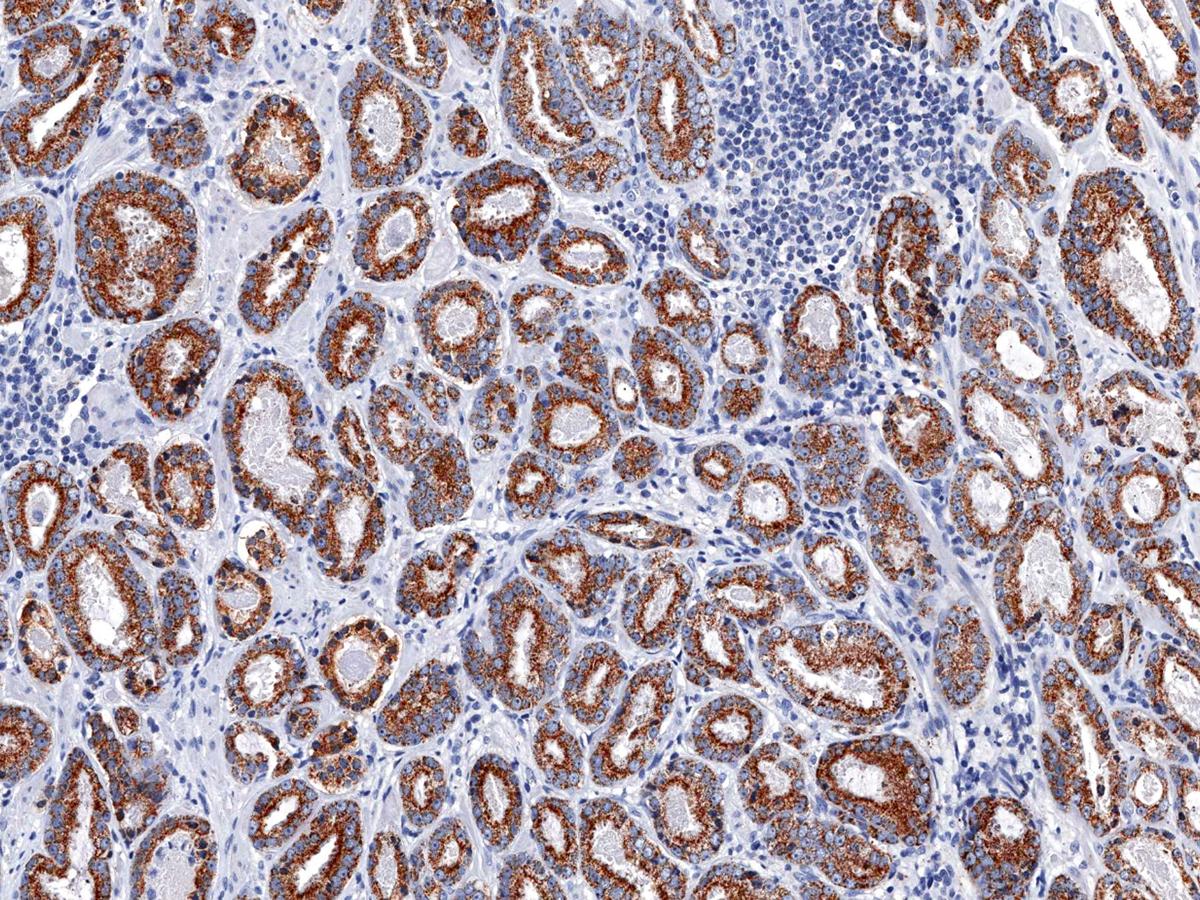

Anti-p504s Monoclonal Antibody (Clone:IHC504)-Ready to Use(Discontinued)
Figure 1: Immunohistochemical analysis of p504s (Clone: IHC504) on Prostate Cancer
Roll over image to zoom in

Shipping Info:
For estimated delivery dates, please contact us at [email protected]
Amount : | 7 ml |
Isotype : | Mouse IgG1 |
Purification : | Protein A/G Chromatography |
Content : | Tris Buffer, pH 7.3 - 7.7, with 1% BSA and <0.1% Sodium Azide |
Storage condition : | Store at 2°C - 8°C. Do not freeze. |
"p504s, also known as Alpha-methylacyl coenzyme A racemase (AMACR), is an enzyme localized in the peroxisome and mitochondria, which functions in Beta-oxidation of branched chain fatty acids, as well as bile synthesis. AMACR has been clinically indicated as a tissue biomarker for prostate cancer and colorectal cancer, as well as high-grade prostatic intraepithelial neoplasia, a precursor lesion of prostate cancer. p504s overexpression has also been detected in a number of other cancers including ovarian, breast, bladder, lung, and renal cell carcinomas, lymphoma, and melanoma."
This product is available in ready to use format, hence no dilution is required.
For Research Use Only. Not for use in diagnostic/therapeutics procedures.
Subcellular location: | Peroxisome, Mitochondrion |
BioGrid: | 117134. 7 interactions. |
There are currently no product reviews
|